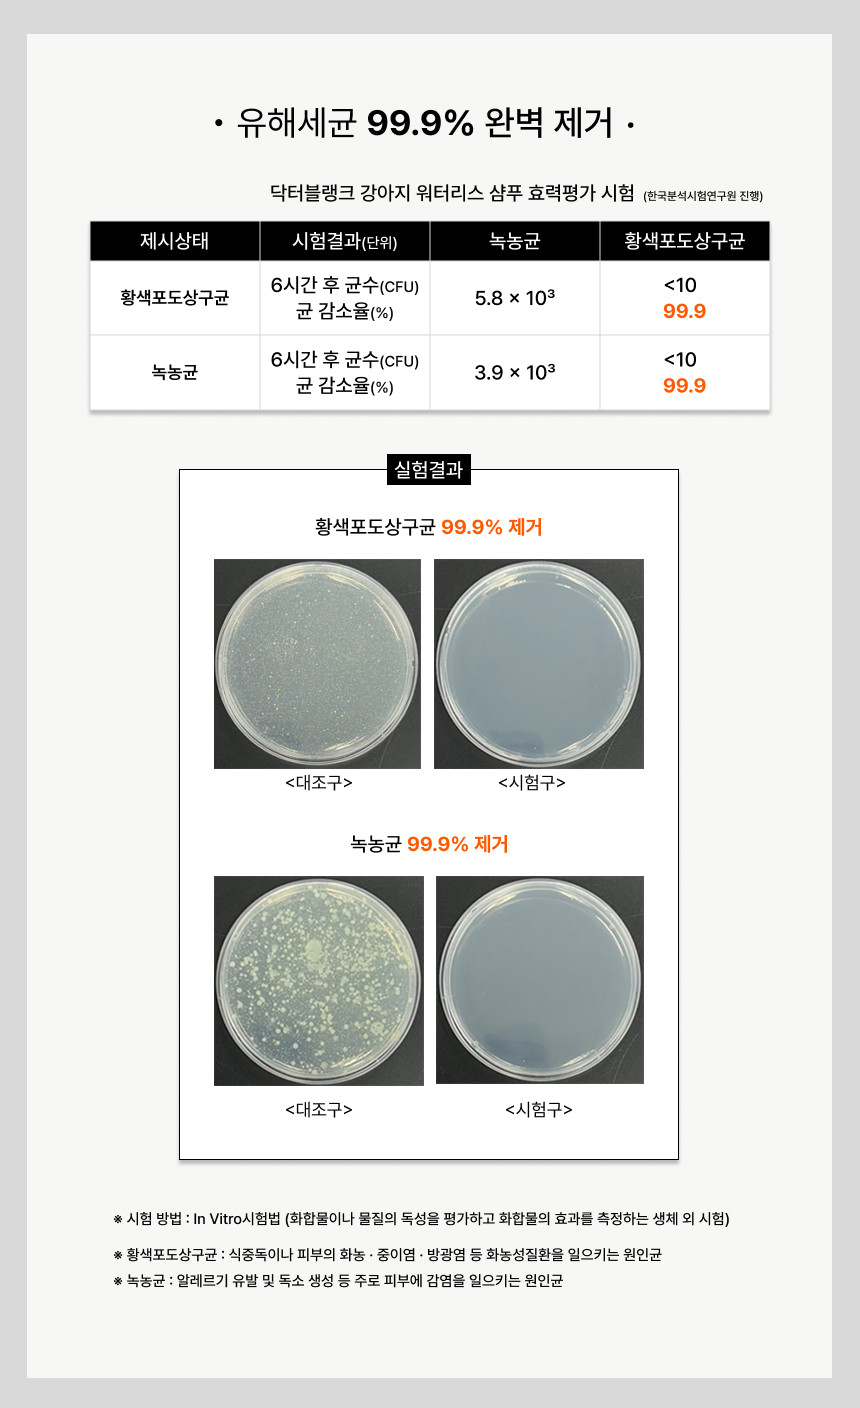

닥터블랭크 워터리스샴푸 200ml
36%
13,900원
- 판매가 13,900원
- 웰컴 쿠폰 할인 -5,000원
- 나의 할인가 8,900원
-
브랜드배송
- 무료배송
- 04월 06일(월) 출발